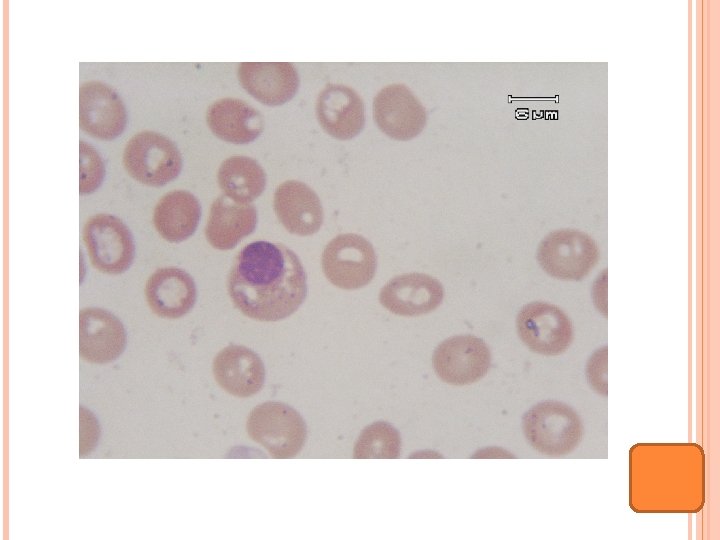
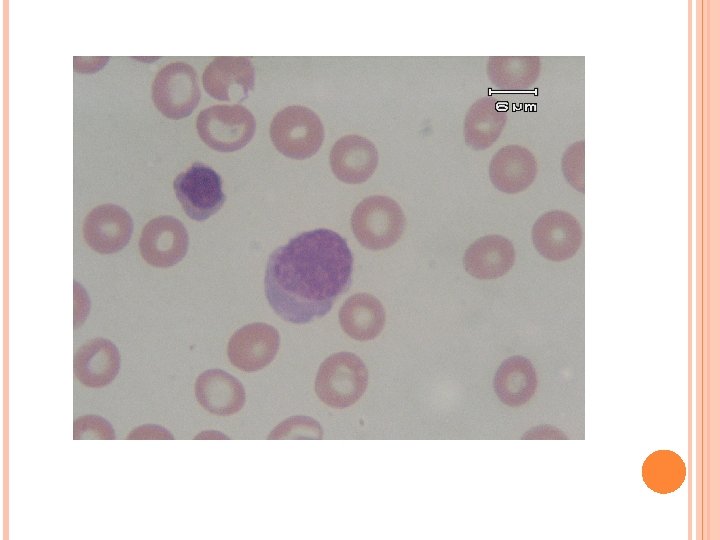
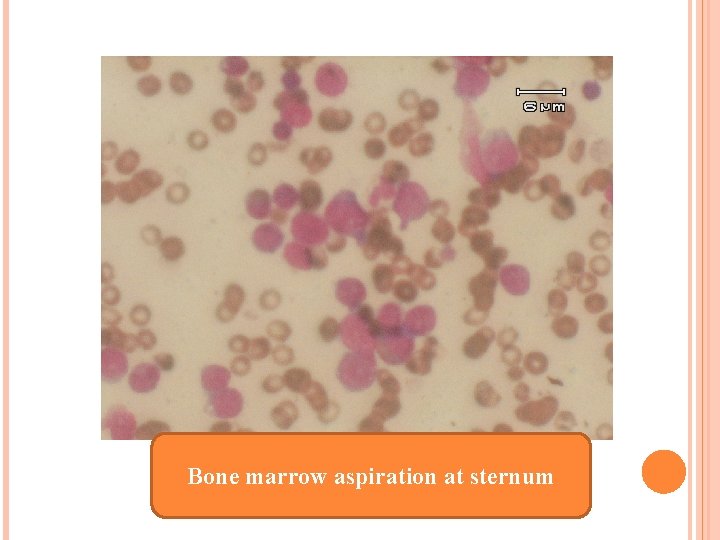
Bone marrow aspiration at sternum

INTERHOSPITAL CONFERENCE 17 NOVEMBER 2009 10 years old

INTERHOSPITAL CONFERENCE 17 NOVEMBER 2009 10 years old boy Prolong fever, arthritis


PRESENT ILLNESS 1 เดอนกอน มาดวยไข 7 วน ปวดขอ ขอบวม SEM at LUPSB, liver 4 cm below RCM Lt wrist, Lt knee and ankle then Rt ankle arthritis (migratory polyarthritis (

INVESTIGATION 1 เดอนกอน CBC: Hct 28. 6%, Hb 9 g/dl, corrected WBC 9, 600, N 37%, L 43%, M 18%, NRC 153/100 WBC, plt 117, 000 MCV 72. 9, MCH 22. 9, MCHC 31. 4, RDW 20. 8 ESR 82 mm/hr, ANA-, ASO positive 1: 1, RF -, CRP + 1: 64, Melioid titer 1: 40, H/C no growth, PPD CXR: mild cardiomegaly EKG: NSR, HR 120/min, QRS axis 750, PR 0. 12 sec, QTc 0. 38 sec, borderline LVH Echocardiogram: EF 76. 8%, mild LV enlargement, trivial MR

Dx: acute rheumatic fever: 1 major (poly arthritis), 2 minor ( fever, ESR, CRP), + evidence Strep infection (ASO+) Rx: cefotaxime x 8 d, amoxy+clavulanic acid x 6 d, ASA gr V (90 mkd) Severe joint pain, pain score= 10 : suspected malignancy/ JRA Brufen, tramol, MST, morphine syrup prn Prednisolone 2 MKD x 2 wk LDH 2, 476 U/L uric acid 6. 3 mg/dl, ESR 135 mm/hr, CRP 1: 16, Coomb’s test –, ANA-, RF-, UA normal eye exam: no uveitis

BMA: inadequate BM biopsy: fragment of cartilage, no bone marrow tissue seen Film bone survey: multiloculated cystic lesion at distal of Lt femur, no osteolytic lesion, suspected benign condition, No malignancy condition Bone scan: ? Ultrasound abdomen: hepatomegaly


PAST HISTORY มเลอดกำเดาไหลเปนๆหายๆ (ตงแตอาย 3 -4 ป ปละ 3 -4 ครง ( 7เดอนกอน มาดวยไข 2 เดอน เบออาหาร ออนเพลย ทองโตขน ซดลง นำหนกลดลง 2 กโลกรม ใน 1 เดอน ตรวจรางกาย พบซด มามโต 10 cm below LCM, CBC: pancytopenia BMA: erythroid hyperplasia, no blast BM biopsy: bony tissue with paucity number of hematopoietic cells without evidence of leukemia Lymph node biopsy at inguinal: reactive lymphoid hyperplasia

PAST HISTORY CT abdomen: diffuse splenomegaly Splenectomy: diffuse sinusoidal hemangiomatosis with extramedullary hemopoeisis EBV Ig M +, Ig. G+, CMV Ig. M-, Ig. G+ Antibiotic 17 days Hb typing: Homozygous Hb E


PHYSICAL EXAMINATION Vital signs: BT 39. 70 C BP 110/70 mm. Hg PR 112/min RR 22/min BW 23 kg (P 3 -10) Ht 130 cm (P 25) GA: A boy, fully consciousness, well co-operate HEENT: mild pale conjunctiva , anicteric sclera pharynx and tonsils: not injected Rt cervical lymph node 0. 5 cm

PHYSICAL EXAMINATION Heart : systolic ejection murmur gr II at LPSB Lungs : normal and equal breath sound, no adventitious sound Abdomen: soft, liver 3 cm below RCM Extremities: no edema Tender and swelling of bilateral elbow, wrist, 4 th, 5 th MCP, Lt 2 nd, 5 th MCP, Rt knee joint

PROBLEM LISTS Prolong fever Polyarthritis Anemia Hepatomegaly SEM gr II S/P splenectomy Homozygous Hb. E

DDX Infection: TB, virus (EBV, CMV), Bacteria, fungus Connective tissue disease: JRA, SLE Malignancy: acute leukemia, lymphoma IAHS LCH

INVESTIGATION

INVESTIGATION CBC: Hb 10. 2 g/d. L, Hct 31%, WBC corrected 4, 900 N 45%, L 36%, M 18%, E 8%, NRC 91/100 WBC, Platelet 131, 000 MCV 85. 7 fl, MCH 28. 2 pg, MCHC 32. 9 g/d. L BUN 5 mg/d. L, Cr 0. 4 mg/d. L, Uric acid 3. 4 mg/d. L Na 139, K 3, 8, Cl 97, CO 2 29 mmol/L, Ca 8. 9, Mg 2, P 4 mg/d. L Albumin 2. 4 g/d. L, AST 54 U/L, ALT 37 U/L. ALP 520 U/L Hemoculture; no growth UA : p. H 5. 5 , sp. gr. 1. 025, wbc 1 -2 , rbc 0 -1 ESR : 75 mm/hr

INVESTIGATION LDH 542 U/L Ferritin 3, 840 ng/ ml B-HCG 1. 11 m. IU/ml, AFP 3. 08 IU/ml ASO-, CRP-, Melioid 1: 20

Bone marrow aspiration

Multiple radiolucency lesions

Ultrasound whole abdomen : diffuse hepatomegaly

BMA: inadequate, rare nucleated cell, no blast Cytochemistry : numerous cell debris and very rare blood cell have been observed, no hematologic malignancy cell : Other cause of bone marrow destruction should be ruled out Flow cytometry: blast gate 2. 63% of total event No evidence of hematologic malignancy

1 st admission

HISTOPATHOLOGY REPORT 1 st admission

Splenic hemagiomatosis (1 st admission)

Splenic hemagiomatosis (1 st admission)

Bone marrow biopsy: Bone marrow necrosis No malignancy cell

Bone biopsy at Lt humerous: Bone marrow necrosis No malignancy cell

BONE MARROW NECROSIS (BMN) Necrosis of myeloid tissue and medullary stroma in the large areas of hematopoietic bone marrow On BM biopsy: disruption of the normal bone marrow architecture with a considerable loss of fat space Aplastic anemia: only loss of myeloid tissue and no destruction of reticular structure Aseptic necrosis: no destruction of the spicular architecture

Hypoxemia after failure of microcirculation: Inflammatory damage or mechanical obstruction : DIC, sickle cell disease or tumor cell plug Immune process Toxicity and the release of toxins, cytokines, or vasoactive substances from damaged cells : TNF Major complication: pancytopenia, embolic processes Repopulation of the bone marrow cavity can occur after BMN resolved

IDENTIFIED UNDERLYING MALIGNANCY 90% Extensive search for neoplastic disease is justified whenever BMN is diagnosed

1 st described by Wade and Stevenson, 1942 : Sickle cell disease, died of cerebral infarction Nies et al. 1965: define BMN in acute leukemia 34/ 316 (10. 75%) postmortem Kiraly and Wheby. 1976: 13/664 (2%) in BM specimens during 12 –year period Norgard, 1979. retrospectively reviewed 120/368 (32. 5%), only 4 were diagnosed at initial

GRADING Small necrotic lesions: <25% of the dimention of the biopsy (39%) Intermediate BMN < 50% (24%) Large BMN >75% (12%) Extensive: throughout the dimension of the specimen Pennaforte et al. 1986: extensive 4/1149 (0. 3%) Maisel etal. 1988: severe BMN > 50% of dimension (3%)

BMN IN CHILDREN Macfarlane and Tauro: 4/379 (1%) in ALL Pui et al: 7/1419 (0. 5%) in cancer patients

BONE MARROW NECROSIS (BMN) ANN M. JANSSENS ET AL. CANCER 2000 Clinicopathologic entity, rare condition Review 240 cases, 1980 -1999 Inclusion 1. BMN diagnosed during life 2. necrosis > 50% of the diameter of biopsy specimen

UNDERLYING DISEASE ASSOCIATION Malignancy 91% Hematologic malignancies 60% Acute leukemia 41%, lymphoma 15% ALL 18%, AML 13% Children 18/25 cases were ALL BMN developed before diagnosis: ALL 26/37 (AML 16/24) After induction chemotherapy 1/37 At recurrence 10/37

UNDERLYING DISEASE ASSOCIATION Solid tumors 30% Not found primary origin, even after extensive search 12/43 Non malignancy only 9%: sickle cell crisis, infection, drug, HUS, antiphospholipid syndrome, DIC, hyperparathyroidism, anorexia nervosa, idiopathic etc. 16/22 documented infection: underlying malignancy were found later (early - 1 yr)

Infection E. coli Streptococcus Staphylococcus Citrobacter freundii Salmonella Mucormycosis Q fever TB Parvovirus HIV Drug Sulphasalazine Sulphathiazol Sulphanamide Interferon-alpha G-CSF ATRA Hydroxyurea Fludarabine

PRESENTATION Bone pain 75% Fever 68. 5% Anemia 91% Thrombocytopenia 78% Leukoerythroblastic picture 51% Elevated LDH, alkaline phosphatase 50%

Leukoerythroblastic picture primitive red cells (nucleated rbc or erythroblasts) primitive white blood cells (myelocytes)

Cytology Bone marrow aspiration can be unsuccessful Multiple aspirates from different sites (sternal, posterior iliac crest, etc. ) Serosanguineous, watery dark red or clear fluid Histology Combination of gelatinous transformation and necrosis of the myeloid tissue Background of gelatinous transformation surrounds cellular debris with indistinct cellular margins, pyknotic nuclei, and abnormal eosinophilic staining cytoplasm The hallmark of bone necrosis: loss of osteocytes, osteoblasts, and osteoclasts

background of amorphous extracellular eosinophilic material that surrounds cells that disintegrate.

shows cells that lose their normal staining characteristics. irregular or indistinct margins; the cytoplasm can shrink or vacuolate, and the nucleus shows pyknosis, karyorrhexis, and karyolysis

Bone Marrow Scanning Technetium 99 m sulfur colloid and indium chloride localize selectively to the reticuloendothelial elements of the marrow Dx BMN, residual BM activity, guided biopsy, recovery MRI: changes in bone marrow signal intensities

Life-threatening complication: embolization of fat and necrotic bone marrow to pulmonary arteries

PROGNOSIS Median survival of the hematologic malignancies : 1 4 months, 69% died Childhood ALL: 13/18 alive Survival: 4 months- 6 years Solid tumor and BMN: widespread metastasis, short survival

PROGRESSION OF THE PATIENT High grade fever Petechiae hemorrhage at face, periorbital Increased hepatomegaly Blood component therapy, antibiotic, pain management Consult for liver biopsy Repeat BMA and biopsy Plan MRI liver and bone Steroid

Hepatomegaly


CBC Hb Hct c. WBC NRC N L M E other D 1 5. 1 15. 9 8. 8 130 50 35 10 5 D 3 6. 7 21 3. 3 200 32 41 13 4 band 2, meta 2, myelo 1, atyp L 5 D 10 6. 1 19. 5 11. 7 80 36 44 16 4 D 15 6. 9 21. 3 4. 1 21 60 30 5 2 band 2 atypl 1 D 16 5. 7 17. 4 3. 9 19 41 55 2 atyp 3 D 17 8. 2 24. 3 4. 9 44 42 52 3 band 2, atyp 1 D 24 7. 4 21. 6 10. 8 31 42 38 9 band 6, atyp 5 D 25 9 26. 8 7. 8 48 38 40 10 band 2, meta 3, myelo 1, atyp 4, blast 2 D 30 7. 4 22 3. 2 50 49 32 9 blast 10 D 31 6. 8 20. 2 9. 2 52 41 47 10 atyp 2 D 35 5. 6 17 15. 1 42 38 10 blast 8, atyp 2 Plt 172 144 27 7 74 21 40 30 49 34 13

Developed massive GI bleeding treatment: LPB, Platelet, FFP, antibiotic Cardiac arrest: CPR x 30 min ABG p. H PCO 2 PO 2 HCO 3 ABE O 2 sat 7. 07 19. 2 444 5. 7 22 - 100 PT INR PTT D-dimer 31. 2 2. 67 34. 4 0. 6 mg/L
Bone marrow aspiration at sternum


BM biopsy from 1. right ASIS: Abnormal blast cells infiltrate with focal necrosis and crush artifact 2. A small amount of marrow tissue from Lt ASIS: abnormal blast cells 3. Sternum: numerous blast cell infiltrate : precursor T lymphoblastic leukemia/ lymphoblastic lymphoma CD 3+, CD 20 -, CD 79 a-, CD 34 -, MPO-, Td. T+


Liver biopsy : precursor T lymphoblastic leukemia/ lymphoblastic lymphoma CD 3+, CD 20 -, CD 79 a-, CD 34 -, MPO-, Td. T+


THANK YOU Extensive search for neoplastic disease Multiple aspirates from different sites : biopsy site in which viable hematopoietic bone marrow
- Slides: 63